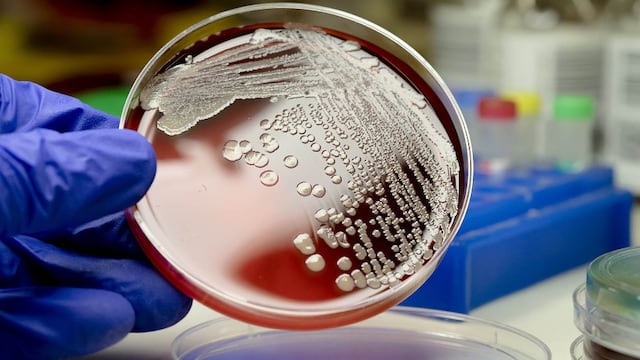
meningitis

A sólo 11 días del Mundial de Qatar 2022, San Juan se va vistiendo de celeste y blanco, para hacerle el aguante a la Scaloneta con todo el cotillón, donde los importes están picantes y con faltantes de mercadería como es la camiseta original de la Selección Argentina.

Si bien las ventas recién comenzaron a moverse, los precios estimativos, como por ejemplo las vuvuzelas, rondan los $300, mientras que las pinturas para la piel rondan los $400.
Sin dudas, lo más requerido a la hora de las compras, es la camiseta de la Selección Argentina donde el debate es entre una alternativa o la original, que por cierto no se consigue.
Por el lado de la camiseta original registra faltantes en las casa deportivas, y lo cierto es que los sanjuaninos y sanjuaninas siguen buscando la camiseta y desde hace dos semanas no se consiguen, que por el momento tiene un costo que supera los $18.000, mientras que las “alternativas del mercado” se consigue una buena imitación en $3500 con escudo sublimado.
Una camiseta para niño supera los $2000, claro, con escudo sublimado o $2.800 con el escudo bordado. Además, la imagen de Lionel Messi, en estampados, es la más buscada como en remeras o vasos.
Cuánto necesitas para comprar la indumentaria completa
Si vas hacer un regalo o querés invertir en la indumentaria completa de la Selección Argentina, incluyendo camiseta, pantalón, medias, botines y pelota oficial, puede superar los $100 mil pesos.
Cuál es el costo de la pelota Al Rihla

La pelota oficial del Mundial Qatar 2022, llamada Al Rihla, en su versión original supera los $20.000 con termosellado y la réplica con costuras a $18.000.
Comparación de cotos en Qatar
Una aburguesa en Qatar supera los $2.000 (en pesos argentinos), mientras que una cena en un restaurante a la carta, cuesta más de $14.000, aunque en un restaurante modesto, supera los $5.000 por almuerzo o cena.